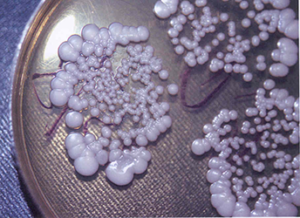

Гриб кандида (Candida) – относится к наиболее распространённым растительным одноклеточным микроорганизмам, которые относятся к роду дрожжей. При этом многие виды кандиды обитают во внутренних органах (или полостях хозяина) подобно паразиту, но в основном составная ее часть присутствует в микрофлоре кишечника, и если там при определённых условиях происходит дисбаланс или иммунодефицит, то это может вызвать болезни.
Гриб кандида (Candida) – относится к наиболее распространённым растительным одноклеточным микроорганизмам, которые относятся к роду дрожжей. При этом многие виды кандиды обитают во внутренних органах (или полостях хозяина) подобно паразиту, но в основном составная ее часть присутствует в микрофлоре кишечника, и если там при определённых условиях происходит дисбаланс или иммунодефицит, то это может вызвать болезни.
Теперь рассмотрим подробнее, такой термин как Молочница или её ещё называют Кандидоз?
Молочница (Кандидоз) – это состояние, при котором происходит поражение всех слизистых (рта, пищевода, кишечника, половых органов), кожи, ногтей и внутренних органов (легких), но при этом носит воспалительный характер, спровоцированный дрожжеподобными грибами рода Candida (Monilia), из которых наиболее условно-патогенные для человека Candida (Кандида) Albicans (85-90% случаев поражения). Источник воспаления размножается почкованием, порождая цепи удлинённых нитей псевдомицелия, слущенных эпителиальных клеток и нейтрофилов во всех тканях куда попадает. Что в дальнейшем может способствовать прорастанию нитей гриба в сосуды, слизистые, тем самым создавая очаги некроза, нагноения, язв, мелких абсцессов, а также стать причиной метастаз.
В особенности такая форма кандидоза наблюдается в случаи хронического течения состояния. Типичный пример заражения организма грибами кандида, это долгое пребывание внутри организма, в виде сапрофитов, не вызывая при этом болезни. Но стоит изменить внутреннею среду (микрофлору и т.д.), температуру тела 37- 40°С (лихорадка, грипп, ОРЗ, ОРВИ), снижение защитных сил, сразу начинает проявляться первичный кандидоз (молочница). Заболевание молочница (кандидоз), получило, такое название по причине, белесоватых (творожистых) выделений из влагалища и образований белого налета на стенках слизистых оболочках наружных половых и внутренних органов.
 Так как развитию молочнице сопутствует иммунодефицит, в особенности это наблюдается у женщин перед началом менструального цикла, поэтому наш организм начинает саморегуляцию по снижению иммунитета. Так как от природы готовится к оплодотворению во 2-ую фазу цикла (прогестерон – гормон сохранение беременности), чтобы принять и развить в своем теле будущий плод ребенка. Но при этом было замечено, что проявление молочницы, тесно связано с циклическим изменением в работе половых гормонов у женщины и обострения молочницы возникают с повторяющими проявлениями за 10 дней до начала цикла. Грибы рода кандида очень любят сахара, мучное и кислую среду, так как это их среда обитания и питательный источник энергии, поэтому всегда стоит обращать внимание на уровень сахара в крови и рацион питания, если у вас на постоянной основе возникает кандидоз (молочница).
Так как развитию молочнице сопутствует иммунодефицит, в особенности это наблюдается у женщин перед началом менструального цикла, поэтому наш организм начинает саморегуляцию по снижению иммунитета. Так как от природы готовится к оплодотворению во 2-ую фазу цикла (прогестерон – гормон сохранение беременности), чтобы принять и развить в своем теле будущий плод ребенка. Но при этом было замечено, что проявление молочницы, тесно связано с циклическим изменением в работе половых гормонов у женщины и обострения молочницы возникают с повторяющими проявлениями за 10 дней до начала цикла. Грибы рода кандида очень любят сахара, мучное и кислую среду, так как это их среда обитания и питательный источник энергии, поэтому всегда стоит обращать внимание на уровень сахара в крови и рацион питания, если у вас на постоянной основе возникает кандидоз (молочница).
Причины возникновения молочницы (кандидоза), под влиянием внешних и внутренних факторов:
-
- Гипертиреоз (гипотиреоз)
- Нарушение углеводного обмена и синтеза белка (гипофункция или нарушение функции поджелудочной железы)
- Длительный, бесконтрольный и без обоснованный прием лекарственных средств (антибиотиков, цитостатиков, кортикостероидов (последнее в особенности для мужчин))
- Использование ежедневных прокладок и тампонов

- Перестройка и изменение в гормональном фоне женщины (беременность)
- Дисфункции в работе эндокринных и половых органов (климакс, и т.д.)
- Прием противозачаточных средств (спреи, гели, мази)
- Антибактериальные средства гигиены (искусственное изменение ph)
- Несбалансированное питание и диеты (преобладание сахаров и углеводов в рационе)
- Дисбиоз/ дисбактериоз кишечника (так как во влагалище, более 40 видов микроорганизмов в особенности условно-патогенных, но 95% из них занимает лактобактерии. То есть палочки лактобактерии (дедерлейна), которые вырабатывают молочную кислоту и антибактериальные соединения, что та в свою очередь создает здоровую среду (3,8- 4,5 ph по кислотно-щелочной школе) и препятствует развитию условно-патогенной микрофлоре во влагалище. Если этот показатель ниже 3,8 ph, то происходит развитие кандидозной инфекции, но если выше 4,5 ph, то это приведет к развитию бактериального вагиноза, поэтому всегда должен быть баланс.

- Стресс – способствует гибели лактобактерий
- Сахарный диабет, лейкемия, рак
- Преклонный возраст
- Ношение синтетического нижнего белья – воздухонепроницаемое
- Посещение саун, бассейнов – нарушение правил личной гигиены
- Иммунодефицит
- Смена климата
- Тяжелое состояние после операций
- Хронические заболевания
- Переохлаждение
- Длительное лихорадочное состояние (выше 38 температура)
- Незащищенный половой контакт
 Симптомы проявления молочницы (кандидоза) в организме:
Симптомы проявления молочницы (кандидоза) в организме:
- Жжение и зуд в зонах половых органах (у мужчин и женщин)
- Дизурия (боль при мочеиспускании)
- Гиперемия
- Боль во время полового акта и диспареуния
- Обильные белые творожистые выделения из влагалища с кислым запахом
- Сухость
- Кандидозный сепсис (возникает при низком уровне иммунитета, при антибактериальных терапиях), так как гриб Candida (Кандида) может циркулировать в кровеносном русле и оседать на органах и тканях, образуя там колонии, но если ситуации запущена, то это может привести и к летальному исходу

- Белый налет на языке
- Кандидозные стоматиты в полости рта
- Высыпания в виде пузырьков
- Кандидозные заяды
- Признаки инфильтрации и нарушения трофики тканей
- Пожелтение и деформация ногтевой пластины на руках и ногах
- Белые пробки в полости рта и на миндалинах
- Покрасневшие участки кожи, шелушение, отечность
- Эрозивные и язвенные поражения слизистых оболочек (толстого и тонкого кишечника, гастриты, колиты), так как Candida albicans, в основном поражает данные участки, что препятствует дальнейшему заживлению слизистых оболочек.
Диагностика и диагностические критерии при (анамнестические, клинические, лабораторные) молочнице (кандидозе):
-
- Наличие специфических и белых выделений из половых путей
- Отеки и покраснения половых наружных органов
- Проверка ph кислотности 4,5 ph (выше) и 3,8 ph (ниже) – тест полоски или исследование в лаборатории
- Микроскопия микрофлоры мазков вагинального отделяемого. При микроскопическом исследовании определяют наличие гриба и его форму, то есть «Ключевых клеток» (псевдомицелий, дрожжевые клетки в количестве 104 КОЕ/мл), сопутствующую патогенную микрофлору (трихомонады, гонококки и др.).
- Мазок на скрытые инфекции и полимеразная цепная реакция, то есть выявление генетического материала (возбудителя)
- Культуральный метод — это бак посев (посев биологического материала) на среду Сабуро, что увеличивает эффективность диагностики при хроническом заболевании, позволяет определить вид гриба и его чувствительность к антимикотическим препаратам.
3 стадии молочницы (кандидоза), которые различаются по степени проникновения и области поражения в слизистую оболочку грибками кандиды.
3 стадии молочницы (кандидоза), которые различаются по степени проникновения и области поражения в слизистую оболочку грибками кандиды.
- Кандидозный кальпит – большие выделения
- Кандидозный вагинит – поражение слизистой оболочки влагалища, отечность в половых органах, болезненные ощущения, меньше выделений
- Кандидозный пиелоцистит – болезненное мочеиспускание, густой налет и язвы
Профилактика молочницы (кандидоза). 4 степени чистоты влагалища женщины:
- Много эпителиальных клеток и лактобактерий. Потому что наружный слой слизистой оболочки отшелушивается и отслаиваются, то есть постоянно обновляется, при этом 3,8 ph (кислая), нет лейкоцитов и нет болезнетворных бактерий
- Единичные лейкоциты, меньше лактобактерий, присутствует пару единиц микробов, но среда кислая 3,7-4,0 ph
- Единичные признаки лактобактерий, лейкоцитов больше, щелочная среда влагалища, присутствует кишечная палочка, стрептококки, стафилококки, иногда трихомонады
- Лактобактерии отсутствуют, много лейкоцитов, много патогенной микрофлоры, среда щелочная.
 Профилактика и рекомендации по оздоровлению при молочнице (кандидозе) от врача-нутрициолога Шабановой Наталье Юрьевны:
Профилактика и рекомендации по оздоровлению при молочнице (кандидозе) от врача-нутрициолога Шабановой Наталье Юрьевны:
- Полноценное питание (витамины, минералы, белки, жиры, умеренное потребление быстрых углеводов), в особенности касается тех, у кого молочница возникает постоянно
- Стоп стресс
- Обоснованная антибактериальная терапия, с последующем курсом пробиотиков для восстановления микрофлоры
- Реабилитация Желудочно-кишечного тракта
- Своевременное лечение острых хронических заболеваний, которые снижают общий и локальный иммунитет
- Контроль гормональных изменений и сбоев
- Соблюдение правил интимной гигиены (к примеру смена прокладок каждые 3 часа, в особенности касается каждодневного применения)
- Смена мокрого купальника во время посещения бассейна, моря, сауны
Противогрибковая схема оздоровления при молочнице (кандидозе) от Шабановой Наталье Юрьевны (врача):

Важно при применении продукции захватить 2 менструальных цикла
1. Острый период при молочнице (кандидозе)
Чтобы получить схему оздоровления при остром периоде молочницы/кандидозе (какие витамины, препараты, травы необходимо принимать и в каких количествах употреблять дозировки) для этого необходимо произвести бесплатную регистрацию дисконтной карты
2. Период стабилизации состояния при молочнице (кандидозе)
Чтобы получить схему оздоровления при периоде стабилизации состояния молочницы/кандидозе (какие витамины, препараты, травы необходимо принимать и в каких количествах употреблять дозировки) для этого необходимо произвести бесплатную регистрацию дисконтной карты
Местное лечение (промывание наружное) при молочнице (кандидозе):
Комплекс сочетания компонентов разных продуктов для спринцевания ли нанесения тампоном пораженных участков половых органов
Во время молочницы и после пропить курс
Чтобы получить схему оздоровления местного лечения (промывание) состояния молочницы/кандидоза и курс дополнительного оздоровления (какие витамины, препараты, травы необходимо принимать и в каких количествах употреблять дозировки) для этого необходимо произвести бесплатную регистрацию дисконтной карты

Противогрибковая программа от Марины Мальцевой при молочнице (кандидозе) и других грибковых инвазиях
Чтобы получить противогрибковую схему оздоровления при состоянии молочницы (кандидоза) (какие витамины, препараты, травы необходимо принимать и в каких количествах употреблять дозировки) для этого необходимо произвести бесплатную регистрацию дисконтной карты
Соблюдение диеты и питьевого режима при молочнице (кандидозе)
Питьевой режим — 30 мл на 1 кг веса человека
Диета строгая на 1,5-2 месяца (курс)
Убрать продукты из рациона питания:
Добавить продукты в рацион питания :
Чтобы получить схему диеты оздоровления при состоянии молочницы (кандидоза) (какие витамины, препараты, травы необходимо принимать и в каких количествах употреблять дозировки) для этого необходимо произвести бесплатную регистрацию дисконтной карты
Чтобы получить схему оздоровления при состоянии молочницы/кандидоза и других грибковых инвазиях(какие витамины, препараты, травы необходимо принимать и в каких количествах употреблять дозировки) для этого необходимо произвести бесплатную регистрацию дисконтной карты